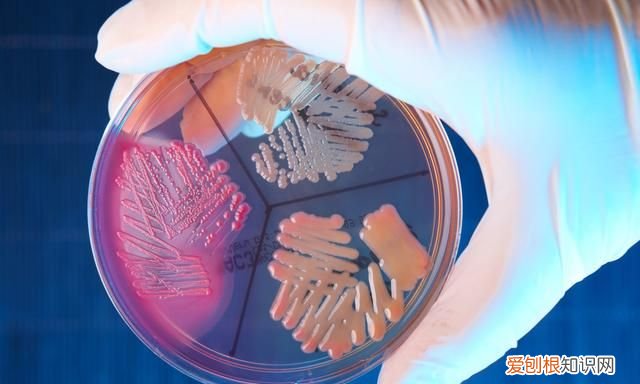
人的脚为什么会臭 出现脚臭的原因

人的脚为什么会臭 出现脚臭的原因
大家好 , 师群民来为大家解答以上问题 。人的脚为什么会臭 , 出现脚臭的原因很多人还不知道 , 现在让我们一起来看看吧!
解答:
1、脚上出汗过多 。青少年多见 , 可能是由于自主神经功能不稳定 , 如情绪紧张导致交感神经过度兴奋 , 或运动导致脚出汗过多 。
2、足部的一些疾病 , 如脚趾间的足部疾病 。
3、穿胶鞋、尼龙袜等透气性差的鞋袜 。
4、或者有些人不注意足部的清洁 , 足部皮肤的温度 , 汗液形成的湿度和头皮屑 , 构成了足部皮肤表面微生物(尤其是厌氧菌)生长、繁殖和腐败的适宜条件 , 汗液中的尿酸、乳酸等有机物分解 , 产生恶臭 。如果你不注意脚的清洁 , 会助长你的臭味 。
5、多汗症 , 脚多汗症 , 同时汗液蒸发不良导致表皮白浸 , 尤其是脚趾间 。重度多汗症可引起水疱、糜烂或角化过度 , 还容易因继发真菌感染引起脚臭 。
6、皮肤受损后 , 会影响皮肤的防御功能 , 使致病真菌更容易入侵定居 , 造成脚臭 。
7、肥胖的人更容易出汗 , 湿湿的脚趾会诱发脚臭 。
本文到此结束 , 希望对大家有所帮助 。
衣服洗干了以后会有一股脚臭是什么原因衣服洗干了后会有一股味道是因为衣服洗完以后没有漂洗干净 , 就会使衣物上面残存的汗液以及洗衣液的味道混合在一起 , 在阳光下经过发酵也就会有一股脚臭味 。
还有的时候比如衣物没有完全干透就收回了捂在一起也会出现一股脚臭味
有的鞋为什么会臭鞋 , 在生活中我们都非常熟悉 , 在日常生活中我们与鞋子的关系是密友 , 陪着我们东奔西跑 , 走街串巷的时候是否会想到鞋底存在安全隐患 。鞋底每天与地面紧密接触 , 又经常跟随人们走家串户 , 流动性很强 , 如果不注意其卫生 , 势必会成为一种可怕的“隐形”污染源 , 充当扩散传播疾病的重要媒介 。

文章插图
穿鞋两周不洗 , 可养46万细菌 。
一项调查显示 , 在接受调查的1176名被访者中 , “买来至今 , 从来不洗”的人占到21.4%;1—2个月洗一次的有5.1%;每年洗一次和每半年洗一次的分别占4.3%和3.4% 。在问及“为什么要洗鞋”时 , 55.6%的人选择了“鞋面很脏”;22.2%的人选择“穿久了 , 鞋内有异味”;10.3%是因为“换季了”;因“经常走路、鞋底有很多细菌”而洗鞋的人只占6.8% 。

文章插图
在另外一项研究中 , 亚利桑那大学的微生物学家Charles Gerba每天都穿着新买的鞋外出 , 两周后 , 他发现鞋底上有42万个细菌 , 另外3000个细菌落在鞋子里 。他令10个参与者重复了这个实验 , 都得到了相似的结果 。
这些被发现的细菌包括:大肠杆菌 , 引起肠道、泌尿系统感染、脑膜炎和腹泻;肺炎克雷伯菌 , 会使创伤口和血液感染 , 以及患有肺炎;鸟氨酸脱羧酶阴性沙雷菌 , 引起呼吸道和伤口感染等 。
文章插图
在鞋子上发现的大肠杆菌 , 96%的来源是因为人们接触了粪便 。这可能是在公共卫生间的地板上碰到或者在室外遇到的动物粪便 。当鞋子被细菌污染后 , 细菌可以在鞋子上停留很久 , 一直跟随你进入到家里 , 如果你穿鞋进入室内 , 还会跟随你进入卧室!
推荐阅读
- 葡萄牙水犬怎么看纯不纯 水犬嘴长吗
- 电焊的原理_电焊的基本方法和步骤
- 海竿和矶竿怎么选择_矾杆与海竿区别
- 微波炉烤肠要几分钟用什么火
- 鼻炎最怕一种食物 如何治鼻炎
- 河南户口所在地行政区划代码查询表 「户口所在地行政区划是」
- 木粉机多少钱一台 木粉机离心刀
- 嘴歪怎么办怎么矫正 如何治面瘫
- 怎么算自己的生辰八字 生辰八字换算器


